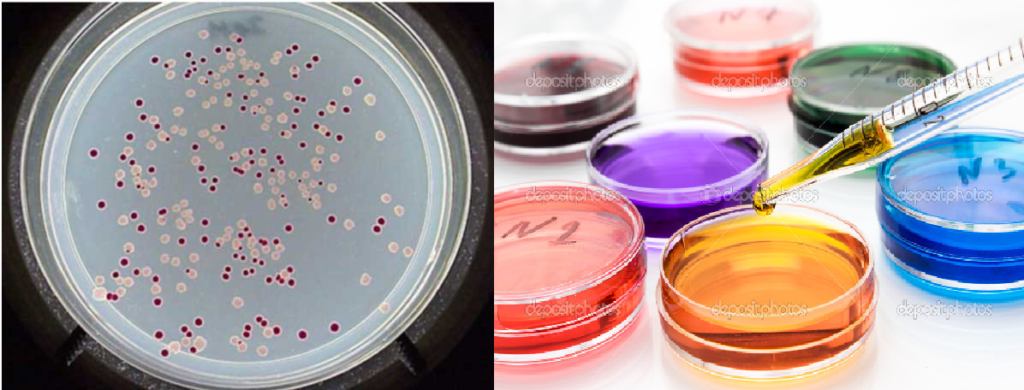

Professor Titular da USP
Bacteriemias
Sua importância, nas cardiopatias e outras doenças infecciosas.

O objetivo de nossos trabalhos sempre foi a proteção da saúde dos pacientes. A proteção do coração, sempre será o foco central, o síbolo de nossas preocupações com a saúde. O coração é a máquina perfeita, que recebe e disbriui o sangue por todo o corpo. Se esse contiver microrganismos, eles serão carreados também, para todos os tecidos e órgãos. Os mais sensíveis, como o endocárdio, as vávulas cardíacas, todo Sistema Endotelial, e as articulações, serão os locaes de menores resistências e as mais afetadas logicamente, pela multiplicação bacteriana.
Trabalho realizado por Professor Doutor Sérgio N. M. Lima e Doutora Izabel Yoko Ito. USP – RIBEIRÃO PRETO, 1975; sobre bacteriemias, nos estudantes de Odontologia.
As bacteriemias mesmo transitórias podem causar: Endocardites bacterianas, algum tipo de reumatismo, e atingir qualquer órgão do corpo humano.

Este é um exemplo clássico de um vaso sanguíneo, conduzindo sangue e bactérias, estado que chamamos bacteriemias. Vemos neste vaso sanguíneo: Hemácias (glóbulos vermelhos), leucócitos (células de defesa – neutrófilos, linfócitos e outras), e bactérias (cocos e estafilococos, como principais exemplos).
A Endocardite Infecciosa ocorre quando há presença de micro-organismos, como bactérias, no fluxo sanguíneo e estas encontram tecidos cardíacos danificados, ou válvulas cardíacas anormais, onde podem se multiplicar livremente, causando uma infecção.
Estudo e prevenção da Endocardite Bacteriana.
Já em 1990, trabalhos feitos na Faculdade de Medicina da USP, de Ribeirão Preto, demonstraram que 5,9% das endocardites bacterianas infecciosas, eram de origem em focos dentários (Ruiz. Jr. Et col. 1990).
Como o diagnóstico de inflamações dentárias evoluíram muito, acreditamos que estes valores se alteram significativamente, na atualidade, por este motivo, no Departamento de Cirurgia da Odontologia da USP, Ribeirão Preto, juntamente com a Microbiologia da Faculdade de Farmácia, resolvemos verificar a incidência das bacteriemias, nos pacientes, mesmo sem alterações patológicas diagnosticadas.
Introdução.
A invasão da corrente circulatória por bactérias oriundas de infecções é conhecida há algum tempo. Entre l920 e l940, algumas investigações foram realizadas para verificar se as bactérias podiam entrar na corrente sanguínea imediatamente após intervenções cirúrgicas. ROBINSON et alii (l950a) realizaram uma ampla revisão bibliográfica sobre a ocorrência dessas bacteriemias após a manipulação de tecidos inflamados.

Este é um esquema dramático e ilustrativo, de uma Bolsa Periodontal ativa na distal de um molar inferior, lançando continuamente, uma plêiade de microrganismos patogênicos na corrente circulatória de um paciente. Os vasos sanguíneos subjacentes à bolsa periodontal, se encarregarão de distribuir, estas bactérias por todo o corpo humano.

As bactérias na correte circulatória, podem causar lesões no endotélio dos vasos sanguíneos coronarianos, o que possibilita sua instalação e multiplicação, formando um biofilme. Esse complexo bacteriano que facilita a deposição de gorduras (colesterol), e consequentemente a obstrução dos vasos sanguíneos e a necrose do tecido subjacente.
Essa invasão é chamada de bacteriemia transitória, porque sua duração varia de minutos até horas após a intervenção (BARTELS, l940, LAZANSKY et alii, l949, COBE, l954). A endocardite infecciosa é uma doença sistêmica, que pode iniciar com uma bacteriemia. Essa, pode ter início com um procedimento odontológico, ou com um processo infeccioso crônico, já existente, há tempos na boca.
Esta etiopatogenia consiste na combinação de dois fatores: 1. Lesão cardíaca, que pode ser congênita ou adquirida, ou um sistema imunológico alterado. Por exemplo paciente com lúpus eritematosos, desta maneira é imperioso a redução da possibilidade de bacteriemias. Para isso a instituição de antibiótico terapia preventiva é indispensável.
Na literatura, encontrados argumentos evidentes de que a manipulação dos tecidos bucais produz bacteriemias transitórias, que podem ocorrer após os mais variados procedimentos odontológicos. São de curta duração e não são clinicamente significativas na maioria dos casos. Contudo, em indivíduos com antecedentes: lúpus, artrites, de febre reumática, alterações cardíacas valvulares congênitas, as bacteriemias, embora transitórias, são potencialmente perigosas, podendo desencadear a endocardite infecciosa, de proporções imprevisíveis.
Referindo-se à endocardite bacteriana infecciosa é causada em 95 por cento dos casos pelos estreptococos do grupo St. salivarius e St. mitis, do grupo enterococos, e estafilocos (espécies St. aureus e St. albus). Esses microrganismos estão presentes nas regiões do nasofaringe, orofaringe e boca, podendo passar para a corrente sanguínea, durante a execução de medidas terapêuticas, inclusive cirúrgicas.
O sulco gengival hígido não é estéril e os estreptococos são os organismos que prevalecem na boca. Quando ocorre um processo inflamatório, o sulco gengival se transforma em bolsa periodontal, nessas circunstâncias a microbiota da área torna-se muito mais complexa e agressiva.
ENGSTROM (l964) mostrou que os microrganismos do grupo enterococos não são somente comuns nos condutos radiculares infectados, mas também na superfície do dente. Observou que os enterococos foram mais frequentes nas amostras dos espaços interproximais e nas amídalas.
Segundo FISH & MAC LEAN (l936), citados por BARTELS (l940), os estreptococos estão sempre presentes no sulco gengival e, na manipulação desses tecidos, caem na corrente sanguínea e linfática da região. OKELL 7 ELLIOTT (l935), demonstraram que a incidência das bacteriemias transitórias, após exodontias, ia aumentando conforme o agravamento da doença periodontal pelo aprofundamento da bolsa periodontal.
Assim, as bacteriemias transitórias estão relacionadas não somente com as exodontias, mas sua ocorrência também é relatada após técnicas de profilaxia, tais como massagens gengivais, remoção de tártaro, curetagens gengivais, entre outros procedimentos.
O interesse despertado pelo assunto foi grande e BENDER & PRESSAMN (l945), KRAUS (l960) e BENDER et alii (l96l) procuraram avaliar quais os fatores que influenciariam na ocorrência e na detecção das bacteriemias de origem dental, abordando vários aspectos, tais como: dentes extraídos, traumatismo cirúrgico, anestesia, doenças periodontais, deslocamentos gengivais, mastigação de cera ou parafina e manobras cirúrgicas menores.
Pelo que se pode observar, ficou estabelecido nesses trabalhos que, após procedimentos cirúrgicos, ou profiláticos na cavidade bucal, há ocorrência de bacteriemias transitórias.
A principal porta de entrada de microrganismos da cavidade bucal é o sulco gengival, e que o meio mais lógico para sua prevenção seria reduzir a flora microbiana bucal em seu próprio habitat. Qualquer procedimento destinado a reduzir a quantidade de bactérias afetará naturalmente a bacteriemia resultante (BENDER, l960).
FELIX et alii (l97l) detectaram bacteriemias em 50% de pacientes com periodontite, após o emprego de ‘WATER PIK’. ROMANS 7 APP (l97l) observaram 7 por cento de bacteriemias, nas mesmas circunstâncias, em indivíduos com gengivite.
Nas raspagens ultra-sônicas, as bacteriemias ocorrem em aproximadamente 72,9 por cento dos casos, segundo BANDT et alii (l964). Os autores analisaram também as bacteriemias que ocorriam após a raspagem manual e não encontraram diferenças estatísticas significativas entre os raspadores manuais e os ultra-sônicos.
REINHART et alii (l982) verificaram se a água usada na irrigação durante a raspagem ultra-sônica, esterilizada ou não, influenciaria na bacteriemia pós-operatória. Vinte voluntários foram usados, raspando-se os hemia-arcos inferiores contralaterais com água esterilizada e água de torneira. A diferença de incidência de bacteriemias após a raspagem com água esterilizada (50,0 por cento) versus a raspagem com água de torneira (53,3 por cento) não foi significativa. O grau de bacteriemias foi semelhante nos dois grupos. Portanto, a irrigação com água de torneira na raspagem ultra-sônica não parece ser um agente causal significativo nas bacteriemias pós-operatórias.
Esclarecendo: Os microrganismos de uma bacteriemia, são destruídos pelos glóbulos brancos, células de defesa, e pelos anticorpos do sistema imunológico. Contudo se esses mecanismos não funcionarem corretamente, os microrganismos não são eliminados e iniciam uma fase de multiplicação, causando uma septicemia ou simplesmente sepses. Que nos pacientes debilitados, é grave podendo mesmo ser fatal.
Notícia do jornal Folha de São Paulo, no dia 28-09-2015, GABRIEL ALVES. Infecções são causa de 30% das internações de quem tem câncer, ou têm seu sistema imunológico alterado.
Um levantamento do Icesp (Instituto do Câncer do Estado de São Paulo Octavio Frias de Oliveira) mostra que 30% das internações de pacientes com câncer se devem a infecções generalizadas (também conhecida como sepse), o que equivale a cerca de 100 pacientes por mês na instituição”.
O objetivo dessa citação, é para o CD, diagnosticar e tratar, todos os focos de infecção da cavidade bucal, o mais criteriosamente em todos seus procedimentos, evitando as bacteriemias.
Nos pacientes imunodepressivos, ou com problemas de sérios de saúde, prescrever antibiótico terapia, antes das intervenções, pois o choque séptico é a forma mais grave da sepse, quando a função dos órgãos já está comprometida.
Por exemplo, o próprio tratamento contra o câncer pode aumentar o risco de infeção, explica o oncologista Fernando Maluf. A sepse atinge 400 mil pessoas anualmente no país e grande parte das pessoas morre por conta de uma demora em iniciar o tratamento –algumas horas podem fazer a diferença.
PROPOSIÇÃO.
A proposição deste trabalho é verificar a ação da raspagem ultra-sônica na placa bacteriana da área cervical dos dentes, supra e subgengival, usando-se como substância de irrigação água destilada, cloreto de cetilpiridínio a l: 4.000 e a nebulização, verificando-se a redução do número de estreptococos e do número mais provável de enterococos. A verificação se fará em vários intervalos de tempo após o tratamento, visando determinar em quais intervalos de tempo ocorre o efeito máximo de limpeza ultra-sônica. Procurar-se-á também determinar as bacteriemias que ocorrem imediatamente após a raspagem ultra-sônica.
MATERIAL E MÉTODOS.

O Cepacol e o nome comercial do cloreto de cetilpiridínio a 1:2.000, foi diluído a 1:4.000, e usado nos experimentos.

Esta é uma das pontas de ultrassom, usada para raspagem. Na fotografia ela esta apenas fazendo a nebulização.
Estudou-se a redução do número de estreptococos e do número mais provável de enterococos (NMP) da área cervical supra e subgengival do dente, determinada por uma técnica de limpeza ultra-sônica, assim como a ocorrência de bacteriemias causadas por essa técnica, por meio de l9.730 culturas realizadas a partir do material colhido em 3l indivíduos de ambos os sexos, com idade média de 23 anos.
Para o estudo das bacteriemias, foram realizadas culturas de sangue antes e após a raspagem ultra-sônica, em 59 indivíduos de ambos os sexos.
SELEÃO DOS INDIVÍDUOS
Foi feita uma seleção preliminar pelo exame clínico de alunos matriculados nas duas últimas séries do curso de Odontologia da Faculdade de Odontologia de Ribeirão Preto, USP, anotando-se em fichas idealizadas com esse propósito, os seguintes dados; nome, idade, sexo, cor, data do exame, dente ausentes e índice de higiene oral. Esses exames foram realizados em consultório dentário, da Faculdade de Odontologia sob boa iluminação, natural e artificial, com auxílio de espelho bucal n 4 e sonda exploradora.
Procurou-se constituir os grupos de estudo com acadêmicos de Odontologia porque o planejamento da investigação apresentava exigências pouco agradáveis, entre as quais jejum absoluto por cerca de 4 horas, abstenção de fumo, consentimento para a colheita de sangue, disponibilidade de tempo, condições estas difíceis de conseguir em pacientes de ambulatório. Além disso, tratando-se de indivíduos de instrução superior, mais facilmente entenderiam as finalidades do trabalho, prestando sua colaboração voluntariamente.
Os voluntários foram selecionados a partir do índice de higiene oral, buscando-se obter maior uniformidade na amostra. Para esse fim foi empregado o índice de higiene oral simplificado, segundo GREENE & VERMILLION (l964).
De acordo com esses autores, esse índice apresenta dois componentes: o índice de placa dental (biofilme) e índice de cálculo. Cada um desses índices, por sua vez, é baseado na determinação numérica atribuída à quantidade de placa ou cálculo presentes na superfície de seis dentes pré-selecionados.
As seis superfícies a serem examinadas para obtenção do índice de higiene oral simplificado (IHO-S) são selecionadas de quatro dentes posteriores e dois anteriores. Para esse procedimento, cada superfície, vestibular ou lingual, é considerada com a metade da circunferência do dente, incluindo, portanto, metade das faces mesial e distal. Neste trabalho foi usado o Índice Simplificado de GREENE & VERMILLION (l964).
Para obter-se a contagem de placa ou cálculo, cada uma das seis faces pré-selecionadas é examinada primeiro para pesquisa de placa e depois para pesquisa de cálculo. A placa dental é o material estranho ao dente, a ele agregado e de consistência pastosa que encerra dextranas e bactérias. Cálculo é o depósito de sais inorgânicos, composto a princípio de fosfato e carbonato de cálcio, misturados com debris, bactérias e células epiteliais. Existem dois tipos principais de cálculo, diferenciados primordialmente pela localização no dente em relação à margem livre da gengiva: supra e subgengival.
Para exame das superfícies é utilizada uma sonda exploradora, para que seja possível observar o desprendimento da placa e a retenção do instrumento pela presença de cálculo. A média individual ou do grupo é conhecida como Índice de Placa Simplificada (IP-S). O mesmo método é utilizado para obter a contagem de cálculo ou Índice de Cálculo Simplificado (IC-S).
O IHO-S, nada mais é que a soma dos índices de placa e cálculo. Assim, o IP-S e o IC-S variam de 0 a 3, enquanto o IHO-S varia de 0 a6.
Para os indivíduos do grupo de estudo das bacteriemias, além do ILHO-S, foram levados em consideração os seguintes aspectos fundamentais:
TABELA l – Valores e critérios observados para obtenção do índice de placa dental simplificado proposto por GREENE & VERMILLION (l964)
Zero (0). Negativo. Perfeita limpeza das superfícies do dente.
Um (l) Presença de placa, sem, no entanto, atingir mais de um terço da superfície da coroa, ou a presença de cálculo.
Dois (2). Placa cobrindo mais de um terço da coroa, mas não ultrapassando dois terços.
Três (3). Placa cobrindo mais de dois terços da superfície da coroa.
Valores e critérios observados para obtenção do índice de cálculo dental simplificado, proposto por GREENE & VERMILLION (l964)
Zero (0). Ausência de cálculo.
Um (1). Presença de cálculo supra gengival, sem, no entanto, cobrir mais de um terço da superfície da coroa do dente.
Dois (2). Presença de cálculo supragengival, cobrindo mais de 1/3 da coroa. do dente, ou presença de pequenos depósitos de cálculo subgengival.
Três (3). Presença de cálculo supra gengival 2/3 da coroa. Ou cálculos sub-gengivais.

Estes são os valores dos índices usados para a placa bacteriana e para o cáculo dental.
ROTINA DE RASPAGEM ULTRA-SÔNICA
A unidade ultra-sônica utilizada foi um Cavitron 600, na sua potência máxima, de acordo com a seguinte rotina de trabalho: Primeiro com a ponta D-3. Fazendo a profilaxia em todas as faces do dente. Em seguida ponta D-10, usada nos espaços interproximais. Finalizando com a ponta D-20.

Estas são as pontas do Cavitron 600, que foram usadas no ultrasson. Esse equipamento de ultrasson, vibra as pontas em uma frequência de 25.000 cps, pelo efeito magneto estritivo das lâminas. A errigação é abundante para evitar aquecimento do sistema.
Nunca se usou pressão excessiva, isto é, o instrumento sempre foi ativado com pequena pressão. O limite cervical de limpeza era o fundo do sulco gengival, porém sem provocar desconforto para o paciente que não estava anestesiado, nesse grupo. Usou-se anestesia em apenas um grupo de indivíduos neste estudo.
Para suprimento do líquido de irrigação do aparelho de ultra-som, usou-se frasco de vidro com capacidade para l000 ml o qual era preso ao teto da sala para dar pressão ao equipamento de ultrassom. Para cada paciente, usava-se aproximadamente 300 ml do líquido irrigante: Os líquidos irrigantes eram: água destilada e solução de cloreto de cetilpiridínio diluição de 1:4.000.
Os 95 indivíduos, selecionados de acordo com o critério descrito, foram distribuídos ao acaso, em 2 grupos, que se subdividiram em 3 subgrupos, da forma apresentada na tabela 3.
Grupo A – Neste grupo estudou-se a alteração do número de estreptococos e a alteração do número mais provável de enterococos da área cervical e do sulco gengival, em 36 indivíduos, assim distribuídos:
Subgrupo A-l – Em l5 indivíduos fez-se a raspagem ultra-sônica, usando-se como solução de irrigação o cloreto de cetilpiridínio a l: 4.000.
Subgrupo A-2 – Foram estudados l2 pacientes, fazendo-se a raspagem ultra-sônica e utilizando-se como solução de irrigação a água destilada.
Subgrupo A-3 – Usaram-se 9 indivíduos, nos quais não se aplicou a fonte de vibrações ultrassônicas diretamente na superfície do dente. Usou-se água destilada que, ao atingir a ponta em vibração, atomizava-se pelo efeito da vibração e pelo efeito cavitacional. As pontas eram então aproximadas de todas as superfícies dentais, gastando-se 300 ml de água destilada para essa nebulização.
Grupo B – Estudou-se a bacteriemia imediatamente após a raspagem ultra-sônica em 59 indivíduos. A raspagem ultra-sônica ou nebulização foi executada em apenas um hemi-arco inferior, direito ou esquerdo, ou seja, naquele em que havia maior número de dentes presentes. Os indivíduos foram assim distribuídos:
Subgrupo B-l – Usou-se o ultra-som apenas para fazer a nebulização da água destilada na região cervical do dente, em l7 indivíduos.
Subgrupo B-2 – Grupo de 20 indivíduos nos quais se fez a raspagem ultra-sônica, usando-se o cloreto de cetilpiridínio a l:4.000 para irrigação.
Subgrupo B-3 – Foi feita a raspagem ultra-sônica, irrigada com cloreto de cetilpiridínio a l:4.000, em 22 indivíduos submetidos à anestesia por bloqueio no hemi-arco a ser raspado com o ultra-som.
Neste subgrupo, anestesiou-se o paciente, com o objetivo de criar condições as mais próximas do uso do ultra-som no consultório, onde na maioria das vezes, o paciente é anestesiado para processar-se a raspagem ultra-sônica. Nessas condições, a ponta ativa do instrumento pode penetrar mais profundamente no sulco gengival ou na bolsa periodontal, o que poderia alterar os resultados da bacteriemias.
Os dados individuais dos 95 indivíduos estudados na presente pesquisa acham-se no apêndice deste trabalho, assim como resultados individuais das contagens dos microrganismos de todos os pacientes do Grupo A.
COLHEITA DO MATERIAL
As colheitas eram realizadas no período matinal. Os pacientes eram previamente instruídos para tomarem seu desjejum e imediatamente escovarem seus dentes sem usar creme dental ou qualquer produto químico. A escovação tinha o objetivo de remover ou eliminar resíduos que possivelmente viriam a interferir nas concentrações, uma vez que as diluições eram feitas em função do peso do material colhido.
Desde a escovação até a última colheita, o indivíduo abstinha-se de qualquer procedimento que pudesse influir na microbiota bucal como, por exemplo, alimentos, medicamentos, fumo e goma de mascar.
A raspagem ultra-sônica ou nebulização era realizada quando decorridas 2 a 3 horas da escovação, precedida da primeira colheita de material dos indivíduos do grupo A, que serviu para a verificação do número inicial de microrganismos e de referência para o cálculo percentual da alteração determinada pela raspagem ultra-sônica.
No grupo B, procedia-se à colheita de sangue, antes de qualquer procedimento.
O término da raspagem ultrassônica servia como referência para se determinar o tempo das colheitas subsequentes. Assim, para o grupo A, os materiais eram colhidos após decorridos 5, l5, 30 e 60 minutos, totalizando 5 colheitas para o mesmo indivíduo. Para os indivíduos do grupo B, o sangue era colhido imediatamente após o término da raspagem.
O material analisado para o grupo A era obtido pela passagem cuidadosa de uma sonda exploradora número 5, na região, cervical do dente e no sulco gengival dos dentes que serviram para avaliação do ILHO-S, tomando-se cuidado para não ferir o tecido gengival.
O material colhido era depositado em um retângulo (20 X l5 mm) de papel alumínio (Rochedo) previamente pesado em balança analítica (Sauter, mod. 404) e acondicionado em placa de Petri (65 X 20 mm). Todo o material utilizado para a colheita foi esterilizado em autoclave.
A ponta da sonda exploradora era passada na área cervical do dente e no sulco gengival, removendo a placa bacteriana remanescente. Tomou-se cuidado para que a ponta da sonda exploradora não produzisse nenhum sangramento no sulco gengival que pudesse interferir no peso das amostras. O material colhido era imediatamente depositado no papel alumínio, com o auxílio de uma pinça, com todo o cuidado, para que não houvesse contaminação das amostras.
PREPARO PARA SEMEADURA
O papel alumínio com o material era, a seguir, repesado e a diferença entre as duas pesagens era tomada como peso do material obtido.
Conhecido o peso, o material era disperso em uma pequena porção de água tamponada para exames bacteriológicos de água, pH 7,2 (AMERICAN PUBLIC HEALTH ASSOCIATION, l955), e disperso com uma raspagem de ambos os lados do papel, com auxílio de sonda exploradora e pinça esterilizadas. A quantidade de diluente utilizada era proporcional ao peso do material, sendo calculada de maneira que cada mililitro de diluente passasse a conter 0, l mg do material (0,000l; isto é, foi adicionada água tamponada em quantidade para alcançar a concentração inicial de l0, a partir da qual era feita, em duplicatas, diluições decimais de l0 até 0,1.
Para obter essas diluições em duplicatas, eram tomados 2,0 ml da diluição inicial de l6 X l50 mm, contendo cada um 9,0 ml de água tamponada. As diluições seguintes eram realizadas da mesma forma, a partir dessas matrizes, em duas séries, tomando-se l,0 ml de cada diluição e transferindo-se para outro tubo contendo água tamponada, após homogeneização, e assim sucessivamente, como poder ser observado na figura 2.
Antes da semeadura e da execução de novas diluições, o inoculo era homogeneizado por pipetagens sucessivas. Foram utilizadas pipetas de 5,0 ml autoclavadas e secas em estufas, após serem embrulhadas individualmente.
CONTAGEM DE ESTREPTOCOCOS
Na primeira placa de Petri temos um número tão grande de colônias que seria impossível, com precisão, contá-las. Assim são feitas diluições de 1:10, para chegarmos um uma placa onde é possível contar as colônias com precisão, e calcular o número de bactérias na colheita do sangue, durante os experimentos.
A contagem dos estreptococos foi feita em placas de Petri contendo ágar (Mitis Salivarius Agar Base – Oxoid CM – l57), meio indicado para isolamento de estreptococos em material que contenha outros microrganismos em alta proporção.
A seguir, o meio foi distribuído assepticamente em volume de cerca de 20 ml em placa de Petri (l00 X 20 mm). As placas assim preparadas foram colocadas em estufas a 37 C, por 24 horas, a fim de testar a esterilidade.
Para contagem de estreptococos, de cada uma das seis diluições preparadas em duplicatas (l0 até l0) era tomado com pipeta esterilizada 0,l ml do inoculo e semeado na placa de Petri. O material era distribuído uniformemente sobre a superfície do meio de cultura, com o auxílio de um bastão de vidro angulado, previamente autoclavados.
Para cada indivíduo, era realizada culturas de estreptococos em 96 placas de ágar mitis salivarius, pela semeadura de duas séries de cada uma das seis diluições nas oito colheitas de material.
As placas eram então incubadas em estufas bacteriológicas (Fanem) a 37 C durante 48 horas.
Para cálculo do número de estreptococos, as colônias de todas as placas semeadas com o material da mesma colheita eram contadas, utilizando-se um contador de colônias Biomatic (mod. 200l). De cada uma das séries, eram selecionadas as duas placas que, semeadas nas diluições maiores, apresentavam número de colônias entre 4 a 300 e a placa correspondente à diluição imediatamente seguinte e anotados em protocolo.
A partir da contagem das colônias, determinava-se o número de estreptococos por miligrama em cada placa e a média do total de microrganismos encontrados nas quatro contagens representava o número de estreptococos existentes por miligrama de material de sulco gengival. Como critério de aferição, era realizada microscopia de esfregaços corados pelo Gram.
ENSAIOS BACTERIOLÓGICOS PARA ESTUDO DAS BACTERIEMIAS
Semeadura das amostras de sangue:
De l0,0 ml de sangue colhidos em cada ocasião, 8,0 ml eram inoculados em frascos de 250,0 ml contendo 80,0 ml de tioglicolato. Os 2,0 ml de sangue restantes eram imediatamente colocados em tubos de l5 X l25 mm, contendo 2,0 ml de solução esterilizada de citrato de sódio a 5,0 por cento. Esse sangue, com anticoagulante, era posteriormente distribuído em porções de 0,5 ml, em 4 tubos contendo l0,0 ml de BNI, e em tubos contendo l0,0 ml de tioglicolato.
Após serem semeados, os tubos e os frascos eram colocados em estufas a 37 C durante 20 dias, sendo que um dos tubos semeados em BHI era colocado em jarra plástica para incubação em anaerobiose (Permution), a qual era obtida quimicamente com envelopes Gaspak (BBL). A condição de anaerobiose era observada com emprego de azul de metileno (BBL).
Isolamento dos microrganismos.
Para o isolamento de microrganismos, a cada 24 horas, os frascos e tubos (BHI e tioglicolato) em incubação eram inspecionados e, daqueles que apresentavam turvação ou suspeita de crescimento, eram feitos esfregaços em lâminas, os quais a seguir eram corados pelo Gram e examinados microscopicamente. Constatada a presença de microrganismos, eram feitos repiques.
No quinto, décimo, décimo quinto e vigésimo dias, independentemente da turvação ou suspeita de crescimento observada pela inspeção diária, todos os tubos e frascos eram examinados microscopicamente e deles também eram feitos repiques.
As hemoculturas eram consideradas negativas quando, ainda no vigésimo dia de incubação dos meios semeados com a amostra de sangue do indivíduo, não se evidenciavam microrganismos nos repiques e nas microscopias realizadas.
Os repiques eram realizados com auxílio de alça de platina e semeados por esgotamento, para obtenção de colônias, em duas placas de ágar sangue de coelho (AsC), duas placas de ágar sangue de coelho com vitamina K (AsCK), em uma placa de ágar mitis salivarius (Ms), ágar hipercloretado com gema de ovo (Ni) e ágar MacConkey (Mc), tanto das inspecionadas diariamente como as de cada 5 dias de intervalo.
O isolamento de microrganismo anaeróbios foi realizado segundo o método preconizado por FINEGOLD et alii (l974). Uma das placas de AsC e AsCK era incubada em jarras para anaerobiose e incubadas a 37 C, por 48 horas. As características macromorfológicas dos diferentes tipos de colônias desenvolvidas eram observadas cuidadosamente. A seguir, os esfregaços eram preparados e corados pelo Gram para observação microscópica.
As placas eram reincubadas em anaerobiose por mais 3 dias, para melhor caracterização das colônias e os repiques realizados em triplicata, nos meios adequados. As outras placas eram incubadas em aerobiose a 37 C durante 5 dias, com observação do desenvolvimento efetuado a cada 24 horas e submetido a exames macro e micro morfológicos corados pelo Gram.
Com base em suas características macro e micromorfológicas, as colônias eram repicadas em meios adequados em triplicata para identificação.
Identificação: As colônias com características morfo tintoriais de estreptococos eram repicadas em tubos de BHI e Hitchens, e incubadas a 37 C. Após o desenvolvimento, eram semeadas em placas de Ms por esgotamento e em placas de AsC, para observação do tipo de hemólise. Estas placas serviam também para controle de pureza das culturas. As cepas de estreptococos cultivadas em BHI e Hitchens eram submetidas a diferentes provas bioquímicas para a identificação, com base nos trabalhos de MIRANDA (l965), DEIBEL & SEELEY (l974) e SYMINGTON (l975).
As colônias com características morfo tintoriais de micrococos eram semeadas em tubos de ágar simples e identificadas segundo BAIRD-PARKER (l974). Os bacilos Gram-negativos anaeróbios eram repicados em tubos de tioglicolato enriquecido (Tiok), e semeados em outra placa de AsCK para a verificação da pureza. Essas cepas eram submetidas a provas bioquímicas para caracterização do gênero, de acordo com SUTTER et alii (l974), HOLDEMAN & MOORE (l974) e MOORE & HOLDEMAN (l974).
As colônias de microrganismos Gram-positivos anaeróbios filamentosos não-esporulados foram pescadas e semeadas em tubos de Tiok e Tubos de AsC. Constatada a pureza da cultura após a semeadura em placas de AsC, a identificação era realizada de acordo com o esquema preconizado por DOWELL & SONNENWIRTH (l974), SLACK (l974), PINE & GEORG (l974) e DAVENPORT et alii (l975).
Os bacilos Gram-positivos aeróbios não-esporulados eram repicados em tubos de AsC. Após a verificação da pureza da cultura por meio de semeadura em placas de AsC, a identificação era feita pela observação do comportamento frente às provas bioquímicas, de acordo com CUMMINS et alii (l974) e HERMANN & BICKHAM (l974). A pesquisa do fator equivalente foi realizada com as cepas conservadas em AsC, reativadas segundo PRESCOTT et alii (l982).
INCIDENCIA DE BACTERIEMIAS APÓS A LIMPEZA ULTRA-SÔNICA
O experimento B – relativo à incidência de bacteriemias após a limpeza ultra-sônica – envolveu 59 pacientes, subdivididos em 3 subgrupos de l7, 20 e 22 indivíduos, respectivamente identificados como subgrupos B-l, B-2 e B-3 (tabela l3). Esses subgrupos referem-se às três condições de tratamento a que se submeteram os pacientes, quais sejam: l) a nebulização com água destilada, sem qualquer outro tratamento; 2) a raspagem ultra-sônica associada ao cetilpiridínio a l:4.000 e 3) a raspagem ultra-sônica combinada com o mesmo cetilpiridínio, porém com o paciente anestesiado.
TABELA l0 – Teste não-paramétrico de KRUSKAL-WALLÍS. Comparação entre os tratamentos realizados.
Valor (H) de KRUSKAL-WALLIS calculado = 9.846l57 2
Valor X para 2 graus de liberdade = 9.85000l 2
Probabilidade de Ho para esse valor de X = – 72% (*)
* Significante ao nível de X = 0,0l
TABELA ll- Teste U de MANN-WHITNEY. Comparação entre números de enterococos nos subgrupos A-l, A-2 e A-3.
A Amostras comparadas Valor de U Probabilidade de Ho (%)
A-l x A-2 0 l,4 (*)
A-l x A-3 0 l,4 (*)
A-2 x A-3 0 l,4 (*)
(*). Significante ao nível de 2 = 0,05
Tabela l2 – Teste não-paramétrico de KRUSKAL-WALLIS. Comparação entre tempo de colheita do material
Valor de (H) de KRUSKAL-WALLIS calculado= 7.6927l9E—02 2
Valor do X para 3 graus de liberdade = 0.08 2
Probabilidade de Ho para esse valor de X = 99.44% (*)
(*). Não significante.
– Todas as culturas realizadas com o sangue dos 59 pacientes, colhido antes das raspagens ultra-sônicas e nebulizações, mostraram-se negativas.
– Quando, porém, o sangue desses, 59 pacientes, foi colhido logo após o tratamento, encontramos 25 culturas positivas (42,2%) nos indivíduos submetidos à raspagem ultrassônica.
– Os resultados finais observamos que em todos tipos de tratamento realizado houve a incidência de bacteriemias (100%).
No Subgrupo B-l – Microrganismo isolado do sangue colhido após a nebulização com água destilada no hemi-arco inferior direito ou esquerdo: Micrococcus lútea.
Subgrupo B-2. Microrganismo isolados do sangue colhido após a raspagem ultrassônica irrigada com cloreto de cetilpiridínio a l: 4.000 no hemi-arco inferior direito ou esquerdo, temos:
Paciente número Microrganismo isolado
25 – Actinomyces bovis
26 – Arachnia propionica, Bacteroides sp.
30 – Actinomyces viscosus
33 – Corynebacterium equi
35 – Actinomyces viscosus, Actinomyces bovis, Streptococcus mitis
36 – Fusobacterium sp.
37 – Actinomyces viscosus, Actinomyces naeslundii
39 – Streptococcus sanguis, Fusobacterium s
Subgrupo B-3 – Microrganismos isolado do sangue colhido após a raspagem ultrassônica irrigada com cloreto de cetilpiridínio a l:4.000 em indivíduos anestesiados.
Paciente número Microrganismos isolados
40 – Actinomyces bovis
4l – Actinomyces viscosus
43 – Actinomyces viscosus
Actinomyces naeslundii
Streptococcus sanguis
44 – Streptococcus mitis
45 – Corynebacterium pseudodiphtheriticum
Streptococcus mitis
46 – Actinomyces viscosus
47 – Fusobacterium sp.
Streptococcus mitis
50 – Fusobacterium sp.
52 – Streptococcus mitis
Actinomyces viscosus
53 – Bacteroides sp.
56 – Streptococcus mitis
Corynebacterium pseudodiphtheriticum
57 – Bacteroides sp.
58 – Streptococcus mitis
Streptococcus bovis
59 – Streptococcus bovis
60 – Actinomyces viscosus
Actinomyces bovis
Streptococcus sanguis
6l – Bacteroides sp.
Incidência e espécies bacterianas encontradas nas bacteriemias positivas que ocorrem após a raspagem ultrassônica, com anestesia.
PARTE B
Em 59 casos estudados, nenhuma das culturas realizadas com amostras sanguíneas coletadas antes da limpeza ultra-sônica ou nebulização foi positiva. Isso evidencia que as bacteriemias observadas após o experimento devem-se à execução do tratamento realizado.
É nossa opinião que, se as culturas foram positivas antes do experimento, estaria havendo falha na colheita de sangue ou na realização das hemoculturas. Poderia ser um caso sistêmico. Se não for esse o caso, ainda assim o paciente em questão não teria condições de participar do estudo, em virtude dessa positividade inicial da hemocultura.
A ocorrência de bacteriemias transitórias, após a manipulação cirúrgica dos tecidos, é conhecida de longa data, ROBINSON et alii (l950a) fazem uma ampla revisão da literatura nesse sentido. Essas mesmas bacteriemias ocorrem também nos tratamentos periodontais que envolvem técnicas de profilaxia, manipulações gengivais, remoções de tártaro, curetagens gengivais e outras intervenções, conforme relatam autores como RICHARDS (l932), COBE (l954), ROGOSA et alii (l960), WINSLOW & KOBERNICK (l960), KORN & SCHAFFER (l962),
GUTVERG & HABERMAN (l962) BANDT et alii (l964), WINSLOW & MILLSTONE (l965) e CORNNER et alii (l967).
LIMA et alii (l984b), ao estudar tecidos inflamados retirados por gengivectomias (ao microscópio óptico e ao microscópio eletrônico de varredura) demonstraram que o epitélio da bolsa periodontal é bastante acantótico, apresentando soluções de continuidade entre células epiteliais devido a degenerações hidrópicas e proteolíticas, e o tecido conjuntivo subjacente apresenta-se intensamente alterado pela infiltração linfo-plasmo citaria. Assim, o menor estímulo físico sobre a parede da bolsa com pouca proteção, colocará as bactérias do sulco ou da bolsa periodontal em contato com o tecido conjuntivo subjacente, instalando-se as bacteriemias transitórias. Quanto maior o grau de inflamação, tanto menor será a resistência natural à penetração bacteriana. É lógico supor então que, quanto maior o comprometimento periodontal, tanto maior serão as chances de as bactérias penetrarem no tecido conjuntivo e atingirem os vasos sanguíneos da região, produzindo as bacteriemias transitórias.
Acreditamos também que o grau de agressão à área considerada pode alterar o número de bactérias que entram em contato com o tecido conjuntivo. Para a realização de raspagens ultrassônica, o cirurgião-dentista, em sua prática diária de consultório, tem na maioria das vezes necessidade de anestesiar o paciente. Assim, para simular o mais possível essas condições clínicas, em termos de penetração da ponta em vibração ultrassônica no sulco gengival, os pacientes do subgrupo B-3 foram anestesiados. Como a área a ser tratada era sempre a mesma em todos os três subgrupos, fez-se sempre o tratamento num mesmo hemi-arco e no mesmo número de dentes. Quando havia falha, esse número pré-estabelecido de dentes era complementado pela raspagem de dentes do outro hemi-arco.
Analisando os resultados das bacteriemias, verifica-se que, no subgrupo doss pacientes em que foi realizada somente a nebulização, houve apenas um caso positivo, mostrando que quando a ponta em vibração ultra-sônica não penetra no sulco gengival, a possibilidade de as bactérias atingirem a corrente circulatória é muito pequena. O único caso positivo desse grupo pode ser atribuído mais à manipulação dos tecidos do paciente (afastamento da bochecha para a determinação dos índices, o uso de afastadores para a execução da nebulização, ou mesmo o uso da ponta do suctor para aspirar a água nebulizada) do que ao tratamento em si.
Quanto aos outros subgrupos experimentais, houve 40% de bacteriemias positivas quando se fez a raspagem ultra-sônica com cloreto de cetilpiridínio a l: 4.000. Nos pacientes do subgrupo que foram anestesiados, ocorreram 72,72% de bacteriemias positivas, mostrando que clinicamente há uma diferença sensível entre o paciente anestesiado e o não anestesiado, pois no primeiro a ponta em vibração ultra-sônica penetra mais profundamente no sulco, aumentando assim, com certeza a agressão ao epitélio dessa área.
Quando se procurou cotejar essa classificação do tipo de bactérias presentes com o tratamento realizado, nenhuma relação foi encontrada, o mesmo ocorrendo no que se refere ao relacionamento das bactérias identificadas com o IHO-S o número de dentes presentes ou a idade do paciente.
A técnica bacteriológica empregada neste trabalho foi executada de modo a torná-la o mais sensível e fiel. Usaram-se meios de cultura, condições de incubação e um esquema de isolamento capazes de detectar a maioria dos microrganismos presentes na microbiota oral, que pudessem atingir a circulação sanguínea. As colheitas de sangue eram feitas logo após o tratamento, porque é nos primeiros minutos de experimento que se observam as maiores porcentagens de culturas positivas.
Segundo KOCK (l922), citado por KHAIRAT (l966), o tempo mínimo necessário para a circulação conduzir germes de alvéolo dental às veias localizadas no antebraço é de l8 segundos. Para outros autores, um minuto é o tempo requerido para que os microrganismos atinjam essa região do braço (LAZANSKY et alii, l949; ROBINSON, l950b; KHAIRAT, l966 e ROMANS & APP, l97l).
Assim, nos pacientes de risco, medidas preventivas cabíveis devem ser tomadas, uma vez que as bacteriemias podem ocorrer independentemente da idade, sexo, tipo de anestesia, saúde periodontal e estado higiênico da boca (KRAUS, l960). GRANDINI (l973), estudando um método de antissepsia pré-cirúrgica para a cavidade bucal, na prevenção da bacteriemia após exodontia, discute de forma clara todos os aspectos relacionados à prevenção, propondo a adoção de uma técnica estudada por ALONSO VERRI (l973).
CONCLUSÕES
Contatos
Rua Visconde de Inhaúma, 590 – conjunto 205. CEP: 14010-100
Localização
Copyright © 2024 | Clínica Sérgio Lima – Todos os direitos reservados